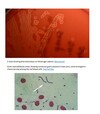

Describe the APVMA, and its purpose ?
APVMA = Australian pesticides and veterinary medicines authority
- no antibiotics are registered for use in Australia
- two are typically used but under minor use permits
- Sates and territories have their own regulations
- many veterinary chemical products are registered for use in companion animals. Most contain products which are banned for use in food producing farmed species
formalin, various antibiotics, anthelmintics and organophosphates

Where would you go to get Veterinary information on how to dispose of dead fish from a nationally significant aquatic disease ?
National investigation and reporting protocols for fish kills.
- fisheries authorities
- Local government council and environmental agencies
-

What is the difference between circling and whirling ?
What is flashing piping in fish ?
Definitions
Circling = controlled blindness ?
Whirling = ‘corkscrew’ uncontrolled neurological disease
Flashing = itchy rubbing against objects / ectoparasites
Pipping = Gulping for air, oxygen poor water, gill disease or anaemia

What can lateral or bilateral exophthalmia suggest in a fish ?
Exophthalmia = protrusion of one or both eyes
It is a common finding of septicaemia, but may also indicate gas disturbances. (high partial pressure of nitrogen).

Discuss how you would take a history for farmed fish ?

Collecting a farmed fish history
Observe before intervening or handling fishthe
1. Affected fish population
2. The cohorts present
3. Environmental conditions
4. The type of containment and the time since establishment
5. Records
- recent introductions
- water and environmental data
- management data
6. Details of specimens submitted and analysis requested

Discuss how you would take the history of a wild fish cull?
Wild fish cull
Sudden death difficult to determine initially whether environmental factors, infectious disease or toxicity is the agent
- history is critical
- submit fish samples and a variety of water samples
- all relevant authorities must be informed
Collect
1. estimate of number
2. Types of fish, one species ?
3. The area covered
4. Range of decomposition
5. water data
6. environmental data
7. weather conditions on the day
Only collect moribund fish - dead fish are far to decomposed
- require many water samples, oxygen, salinity, hardness and PH
- fill water samples to overflowing
Contact the testing laboratory prior to testing sampling methods differ and containers may require pretreatment.

How would you recommend taking algae samples ?

Algal blooms
Algal blooms tend to concentrate at different depths in the water so collect from varying depths
Quantitative = estimate number of algal cells per litre
Qualitative = strain through a net to identify the algal species

Describe how you would calculate the condition factor ?

What is the purpose of the aquatic manual and aquatic code ?
Aquatic code
Aquatic manual
Used in International trade as the main source of standards
- official diagnostic methods
- declaring freedom from disease

What tissues would you target for viral, bacterial or histopathology ?
What tissues to sample
Typically samples from 5-10 clinically diseased fish
Viruses
- appropriate organs are the anterior mid kidney, spleen, liver and heart or encephalon
- fry remove the yolk sac
Bacteria
- kidney, brain or eye
Histopathology
- Formalin migrates about <0.5cm an hour sample may be fixed whole
- fixatives will not penetrate rapidly into larger fish with abdominal diameter >0.5cm
- fish <10cm may be fixed whole with abdominal flap and gill cover removed to ensure penetration
- preferable deflate the swim bladder to ensure penetration of the kidney
- samples should be no thicker than 1cm in two dimension
In
- larger fish it is more practical to select tissue samples
- target visible lesions plus general organs and tissues.
- gills, skin, liver, kidney, brain and eye
1:10 parts tissue : fixative

What bacteriology culture is a good all round media for fresh water / marine sites ?

What notifiable disease would you need to rule out after sighting a red ulcer on the side of a fish ?
epizootic ulcerative syndrome EUS
a reportable fungal disease of International concern
WOAH and Australian notifiable disease

Describe the three kidney in fish and how the different parts function ?

Fish kidney
The fish kidney has both immunological and acts alike to mammalian bone marrow
Head kidney / Pronephros
Corticosteroids and major site of antibody production
- haemopoetic functions and aglomerular
- highest concentration of B lymphoid cells
- principle immune organ responsible for processing and formation of IgM and immune memory through melanomacrophage centres (MMC)/
- also acts as an important endocrine organ
Homologous to mammalian adrenal glands = releasing corticosteroids and other hormones
Capsulcles of Stannius
Posterior kidney
- both renal and immune tissues
- huge variation with some species not having glomeruli

What is the major secondary immune organ in fish ?
What organ produces T lymphocytes in fish ?

The spleen
Major secondary immune organ
- abundant antibody production IgM and mature B cells
The spleen plays a major role in antigen trapping and presentation.
- clearance of blood born antigens and immune complexes
- initiation of the adaptive immune response
The organ which produces T lymphocytes in fish
Thymus
- stimulates phagocytosis and antibody production by B cells

Describe the principles of fish vaccination ?
The principles of fish vaccination
1. Only vaccinate healthy fish
2. No food 24-48 hours prior to the vaccine
3. Disease free environment during the vaccination period
4. The vaccine must precede exposure to the disease
5. Transfer to a disease prone site only after the appropriate time lag phase.
Other aspects to vaccination
1. The smaller the size of the fish - the greater the risk of local reactions
2. higher temp increase risk of local reactions
3. Onset of immunity is temperature dependant
(Poikilothermic = water temperature dictates metabolism)
4. Adjuvants
(Various adjuvants have been tried out but oil based remains the best).
Type and number of antigens - monovalent vrs multivalent.
Only use an injectable vaccine in fish which are over 10g.

Describe the non specific defence mechanisms that fish can utilise ?

Non specific defence mechanisms
Mucous, skin, sacles and melanocytes
Surface barriers - mucous
- the skin, gills and gut are covered by a layer of mucous which is continually sloughed off inhibiting colonisation be pathogens.
- contains some principles which are toxic to micro organsisms IgM
- mucous production will increase in response to inflammation or fin rot
Skin
Integrity is crucial to maintaining osmotic balance and excluding microorganisms
- epidermis is non keratinised and nucleated
- healing is rapid even at low temperatures
- Malpighian cell migration from the periphery of the wound - different from mammalian scab formation
- can provide an almost immediate barrier
MALPIGIAN CELLS ARE AMONG THE FASTEST MOVING CELLS KNOWN.
Scales
Scales are the dermis sitting under the epidermis
- scales on your hand/net means significant damage
Melanocytes
Melanin plays a role in immune functions
- melanocytes respond to cytokines including interferons, interleukins and tumour necrosis factor.
- leukocytes can produce melanin, playing a role in inflammation
in fish
(melanin present in fillet of farmed salmon is a considerable quality problem - affecting up to 20% of fillets.
- fish scars in contrast to mammals chronic inflammation in fish may appear with abundant pigmentation.
Chronic inflammation in fish often presents as hyperpigmented ‘dark’ fish = poor doing

What is a melanomacrophage centre ?

Melanomacrophage centre
A second group of melanin producing cells are called MELANOMACROPHAGE.
- often seen in groups or centres MMCs (melanomacrophage centres)
- ## increased numbers of MMC can indicate stress or disease in fish

Why is haematology of limited use in fish ?

Haematology - study and treatment of blood
Limited use as an indicator of disease in fish
leucocyte response, automation, only small volumes, poikilothermic
- leucocyte responses to disease can be slow
- leucocyte response to stress and handling can be very rapid
Therefore we may be more likely to detect an affect of handling rather than an affect of disease. - nucleated erythrocytes and thrombocytes - blood counts can not be automated, other than total blood cell count.
- can only collect relatively small volumes of blood
- Poikilothermic - blood cell enzymes operate over a larger a temperature range. (mammals temp drop reduces enzyme activity)
- fish blood cells continue to be active (enzymatically and osmotically) may result in huge changes during transport of mean erythrocyte volume (packed cell volume).

Describe the common immune system cell types of fish ?

The common immune system cell types of fish
Macrophages
- widespread mainly kidney, spleen and cardiac atrium
- monocytes (kidney) 1-3 days in blood before entering tissues as macrophages
Neutrophils
- kidney spleen and blood
- phagocytic, chemotactic and bactericidal
- phagocytosis enhanced by opsonins and cytokines
Natural cytotoxic cells
- can kill certain cell types, ie when infected with avirus or bacteria
- without a need for previous exposure
Granulocytes
- Eosinophilic granular cells (EGCs) roughly equivalent to mast cells
- degranulate = serotonin
Some fish eg carp have been demonstrated to have basophils.

Describe inflammation in fish ?

Describe the immune defence of crustaceans ?

The defence mechanisms of crustaceans ( innate immunity)
Defence factors
cuticle/surface, semi closed circulatory system, copper based hemocyanin, hemocytes and (lysozyme and Penaeidin).
Surface = harbours a microflora which inhibits the growth of virulent pathogens
Cuticle = protective layer comparable to fish scales
Semi closed circulation system
- no separation between the circulatory and lymphatic system
- coregulation of circulation/ respiration preventing a ventilation perfusion mismatch.
(hypoxia ventilation down, HR down)
Copper based hemocyanin
- free in the extracellular fluid (not bound to a blood cell)
Hemocytes
- the only immune cell type
- main site of immune function
Lysozyme and Penaeidin
- common antimicrobial peptides (AMPS) which destroy microbial cell wall by hydrolysis.
- commonly expressed by hemocytes
What they lack
- immunoglobulins
- complement factors

Describe the cellular response of shrimp to a pathogen ?

Only one immune cell type Hemocytes
Main site of immune function
Hemocytes carry out the function of both red and white blood cells
- hyaline, semi granular and granular cells
A cellular response hemocytes - is initiated by a cascade of prophenoloxidase (proPO) activating systems leading to
phagocytosis
encapsulation
- several hyaline hemocytes act cooperatively to attack an enormous microbe
nodulation
- several hyaline hemocytes react cooperatively against many small microbes.
coagulation
melanisation of intruding pathogens.
Lysozyme and Penaeidin
- common antimicrobial peptides (AMPS) which destroy microbial cell wall by hydrolysis.
- commonly expressed by hemocytes

Why is apoptosis important to immune function in shrimp?

Apoptosis - killing of infected cells
This process is carried out be cell proteases
- important regulatory approach of prawns and shrimp
- proteases paly an essential role by receiving external signals and initiating apoptosis
By regulating apoptosis the host can eliminate cells infected by pathogens - thus killing and limiting the spread of pathogens.

What is HPS and immune priming why is it important in shrimp?
Shrimp immunity
Heat shock proteins
- proteins produced in response to heat shock play an important role in protecting many organisms from any sudden change in the cellular environment which would damage proteins.
- induced by change in temp, organic molecules, pollutents and oxygen deficiency
- found in all tissues
- HSP have been associated with the inhibition of viral replication
Immune primming
Distinguishes the phenomenon of some memory like properties in hemocytes alike to (macrophages NK cells in the immune system of animals).